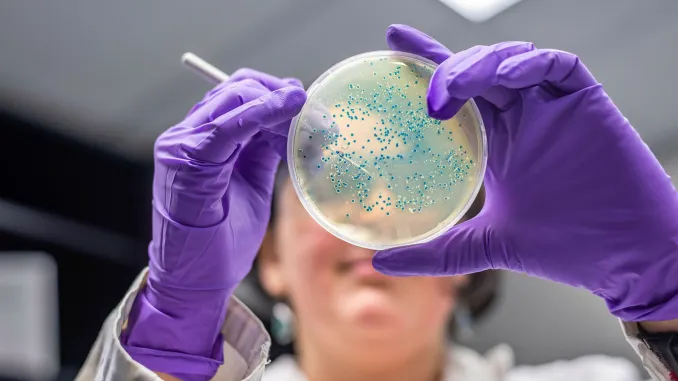
Sessiz Pandemi: Antimikrobiyal Dirençle Küresel Mücadele ve Tek Sağlık Yaklaşımı

Avrupa Birliği’nin Gıda Güvenliği Hareketine Türkiye de Dahil Oldu
Tarım ve Orman Bakanı İbrahim Yumaklı, Avrupa Birliği’nin (AB) gıda güvenliği otoritesi EFSA tarafından yürütülen “Safe2Eat” farkındalık kampanyasına bu yıl Türkiye’nin de katıldığını açıkladı. Bakan Yumaklı, EFSA tarafından 2020 yılından bu yana sürdürülen kampanyanın, gıda güvenliği konusunda kamuoyunda bilinç oluşturmayı...
Yazıyı Oku